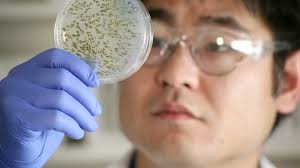

bitcoin tilt

Two years ago, when the crowdfunding app Tilt had just scored a key partnership to be the default payment system for ESPN’s fantasy football and basketball leagues, co-founder and CEO James Beshara said in a Fortune interview that Tilt wasn’t really competing with the red-hot payments app Venmo, since Tilt was aimed at collecting money from a group.He also argued Tilt felt more social.“Venmo works for one-to-one, but when you really want a social product,” he said, “it’s like the difference between e-mail and Facebook.” The suggestion: Venmo can do its friend-to-friend thing, while Tilt will stay in its lane of group payments.Now, four years after Tilt’s founding, it is finally going straight after Venmo, as any user could have foreseen.Tilt announced on Tuesday it is adding a 1:1 payments option, “making it easier for users to automatically send and request money on a more bite-sized scale,” a spokesperson says, “from sending money to a friend for rent or a round of drinks, to requesting money for a movie ticket or last night’s Uber.” Tilt launched in 2012, has raised a fat $62 million in venture funding from the likes of Marc Andreessen, Ron Conway, Sean Parker, and the rapper Nas, and it is seeing 41% growth each month on college campuses, where the app has caught on thanks to a student ambassador program.

But this will be Tilt’s true coming out party.Tilt originally worked like this: You are holding an event (one of the most popular uses: kegger), or buying a gift, or ordering merchandise, and need to collect money from a group of people.You set a minimum target amount, and when the group hits the target (when it “tilts,” get it?)It isn’t unlike a Kickstarter or Indiegogo campaign, but more utilitarian than artistic (though some brands have used Tilt to gauge interest in a new product).Some have called Tilt “micro-crowdfunding.” The funding can take place on Tilt’s web site or its mobile app.The group focus helped Tilt gain steam among millennials.The service is in nine countries and won’t share users or revenue, but says it is growing its user base 4x year over year.If you haven’t heard of Tilt, it is likely because you don’t often have a need to solicit money from a group, or when you do, you use a more traditional method.Collect cash from everyone in person.)Or you could be using Venmo, which, even though it operates on one-to-one transactions, allows you to enter an amount and then charge multiple friends the same amount at the same time.

This couldn’t have helped Tilt much.Adding the Venmo-like feature will elevate Tilt to the next level of utility.
bitcoin wallet windows phone 7But competing with Venmo, which is owned by PayPal (after PayPal acquired Venmo parent company Braintree in 2013), will be no picnic.
sms na bitcoinVenmo’s transaction volume grew 154% in the Q1 of this year to $3.2 billion.
bitcoin benefit or curseAs Re/code pointed out, Venmo is “growing ridiculously fast.“But if Tilt can convert its college students away from Venmo, it could become a one-to-one payments player quickly.
bitcoin vinAs Tilt began to launch into more international markets, “We kept getting the request from our users to add in 1:1 payments,” says Beshara, who avoids naming Venmo specifically.
ethereum nasdaq

“Then we looked at the data, and almost 20% of our usage in the UK was due to people bending Tilt, an app built for more social and group-oriented activity, for 1:1 payments.” That is: Tilt users were already trying to use Tilt as a Venmo anyway.
bitcoin qt fasterTilt began testing a 1:1 option in January, and among the testers, it led to a 34% increase in group Tilts.Venmo isn’t the only competitor in the peer-to-peer mobile payments game.
bitcoin per paypal zahlenThere’s Xoom (also owned by Venmo), Square Cash, Google Wallet, TransFast, Dwolla, Circle (which uses the bitcoin blockchain), and TransferWise (for sending money internationally only), to name a few.Tilt’s version of 1:1 payments has some distinguishing twists: Tilt automatically transfers funds to your bank account each day, rather than holding them in your Tilt wallet; Tilt allows both domestic (US to US) and international (abroad to US, but not US to abroad) payments, while Venmo is only for US to US; payments are free if using a Visa or MasterCard debit card, Tilt gets a 3% fee if you use a credit card.Beshara doesn’t see mobile apps as his competition anyway—or he isn’t saying so.
poker withdraw bitcoin

He lists Tilt’s competition as: “Cash, checks, and bank transfers globally.” The bank transfers move through giants like Western Union, Wells Fargo and Citi, still the top dogs in money transfers for now.
bitcoin etf march“The world,” he says, “is still just beginning to wake up to digital payments.” —Daniel Roberts is a writer at Yahoo Finance, covering sports business and technology.Follow him on Twitter at @readDanwrite.Read more:These 3 very different apps helped me save moneyTransferWise enters the hot US-to-Mexico payments marketI got six parking tickets in NYC in one week– and beat them allMeet the Reddit-like social network that rewards bloggers in bitcoinWhen the internet was first created in the 1970’s and 1980’s with the introduction of the ARPANET its early years were focused on the development of infrastructure and protocol — beyond the knowledge and far away from the consciousnesses of the general public.

The establishment of that foundational protocol allowed for a subsequent wave of application layer innovation in the late 1990’s and early 2000’s that has come to dominate the public consciousness (e.g., Google, Facebook, Amazon, etc.).Even though technology at the protocol layer created a ton of value, the application layer has ultimately captured most of the mindshare and the value.Meanwhile, the television industry has seen a different, but related, phenomenon play out.For many years, cable operators and telcos served as intermediaries between consumers and content.They bundled packages of cable networks and sold them as monthly subscriptions.But with the proliferation of high-speed internet in the household, companies like Netflix began to instead sell and deliver content directly to the consumer, avoiding cable distribution entirely.This has become known as “over-the-top” television and is increasingly driving an unbundling of content.The same patterns are emerging in financial services.

New consumer-facing financial applications are being built on top of old banking infrastructure, while other startups are going around financial infrastructure altogether.Together, they are unbundling the roles of banks and other financial incumbents.In recent years, financial services architecture has opened up in a way that we have never seen before.Data APIs like Yodlee, Plaid, and Quovo now make it easy for developers to pull user financial data.SDKs like Card.io make it easy to onboard payment cards into mobile apps, financial market APIs like Xignite pull live stock prices, and payments APIs like Braintree and Stripe make it simple for developers to accept payments.The combination of this development at the infrastructure layer, with what my partner Sarah Tavel notes as the growing distrust of traditional financial institutions, has created an opportunity for fintech startups similar those in internet and television: to create application layer companies with massive mindshare and value capture without having to innovate at the infrastructure layer themselves.

And while some of these startups may piggyback on open financial architecture, others avoid traditional pipes altogether and go completely “over-the-top”.In fact, the next billion dollar fintech startup may not look like a traditional fintech company at all.Here are a handful of areas where I expect we’ll see these patterns play out: Transferring money between two parties was one of the earliest problems to plague peer-to-peer commerce on the web.Paypal was the first breakout success in this category when it created a payment system that enabled transactions on eBay, and it remains an important part of financial infrastructure today.With the advent of mobile, a new crop of startups emerged to enable p2p money transfer beyond commerce: Venmo in the US, Verse in Europe, and Toss in Korea, to name a few.These applications have not only created sticky social networks, but have also habituated consumers to exchanging value back-and-forth via mobile.In doing so, they have created an opportunity for a third wave of innovation within social finance.

For example, Tilt enables users to collect money from friends in a simple, friction-less way.Tilt didn’t have to rebuild the financial piping it was able to build on top of Stripe and focus its innovation on user experience and social functionality.Splitwise allows individuals to split expenses and exchange value via a shared cloud-based ledger.Splitwise takes p2p money transfer over-the-top: like Bitcoin, it enables users to exchange value with bits (debits and credits to a ledger) instead of financial pipes, and unlike the p2p money transfer apps can be global from day one.But what about settling into real money?Rather than rebuild payment pipes, Splitwise allows its users to settle via its integrations with Venmo and PayPal, which are increasingly open architecture themselves.In the past, creating a new wealth management offering required some heavy lifting: new entrants would have to build a clearing firm, connect to market exchanges, build and become licensed as broker-dealers, and then establish relationships with RIAs to secure distribution for the product.
But recently this ecosystem has been vastly simplified and startups no longer need to develop the entire stack themselves.Apex opened their clearing firm and onboarding tech to other broker-dealers, enabling startups like Robinhood and (our portfolio company) Wealthfront to launch new financial offerings.And now there is a second wave of infrastructure development simplifying the wealth management stack even further: broker-dealer APIs.Companies like Tradier and Third Party Trade enable startups to avoid building the broker-dealer altogether and focus on developing a differentiated customer experience.Another example is Trigger, an app that sets “if this then that” rules for trading.Interestingly, Trigger doesn’t have any financial infrastructure at all— it’s a rules engine that sits on top of brokerage accounts, yet it is quickly becoming a primary trading window for its users.Among financial service verticals, insurance stands out in its ability to resist change.Yet even here there has been an opening of the industry architecture that has begun to allow for a new wave of innovation.

For instance, re-insurers like MunichRe and SwissRe have begun to partner with startups using Managing General Agent (MGA) structures.In an MGA the re-insurer maintains the balance sheet while the startup focuses on customer acquisition, experience, and product design.Such structures have enabled the emergence of startups like Ladder in life insurance, Hippo in home insurance, and Jetty in renters insurance.On the other hand, several startups are utilizing p2p networks to, at least partially, go over-the-top of traditional insurance balance sheet providers altogether.Lemonade here in the US and Friendsurance in Europe are examples of this approach.By doing so, they create greater alignment of incentives, reduce fraudulent claims, and save money for their policyholders.The most striking example of over-the-top fintech is Bitcoin.By design, it is a system of record that avoids intermediation by traditional financial institutions and instead allows for value transfer directly between two parties.